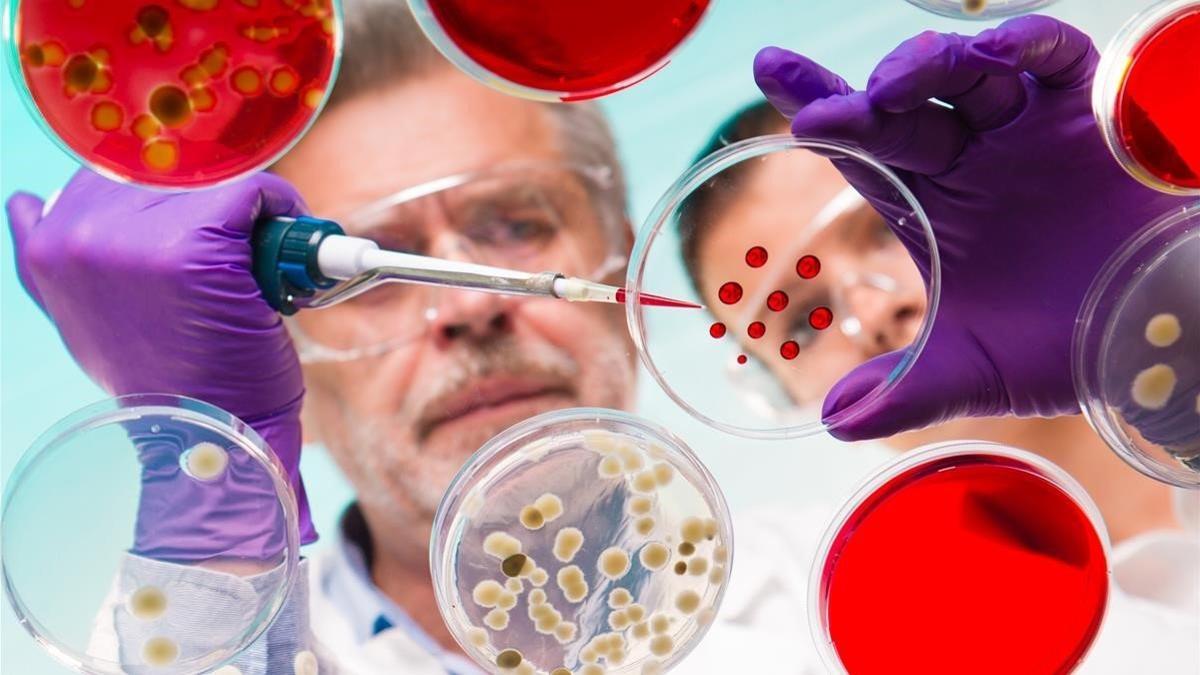
jcarbo45329812 arca de noe181004144733

INICIATIVA INTERNACIONAL
Llamamiento para crear un Arca de Noé de microbios por el bien global
jcarbo45329812 arca de noe181004144733
La biodiversidad del planeta está amenazada. Las primeras señales de alerta se hicieron visibles con la desaparición de animales y vegetales del mapa terrestre. Especies que durante siglos habían poblado la Tierra pero que con la llegada del hombre se habían visto marginadas, amenazadas y extintas. Pero más allá de estas pérdidas más visibles, la amenaza a la biodiversidad alcanza al mundo microscópico. Y es por ello que ahora un equipo internacional de investigadores hace un llamamiento para crear un "Arca de Noé de microorganismos" en la que conservar aquellos elementos esenciales para la salud humana.
La iniciativa, hecha pública este jueves en la revista 'Science', reclama la creación de una "bóveda microbiana global" en la que almacenar muestras de todos los gérmenes beneficiosos para las poblaciones humanas que actualmente se puedan ver amenazados por las circunstancias externas. Una iniciativa que, por el momento, cuenta con el respaldo de investigadores como María Gloria Domínguez-Bello (Universidad de Rutgers-New Brunswick), Rob Knight (Universidad de California-San Diego), Jack A. Gilbert (Universidad de Chicago) y Martin J. Blaser (Centro Médico Langone de la Universidad de Nueva York).
"Nos estamos enfrentando a una creciente crisis de salud global que requiere que capturemos y preservemos la diversidad microbiana humana mientras aún existe", explica María Gloria Domínguez-Bello, impulsora de esta nueva iniciativa e investigadora del departamento de Bioquímica-Microbiología y Antropología de la Rutgers-New Brunswick University. "Estos microbios evolucionaron conjuntamente con los seres humanos durante cientos de milenios. Nos ayudan a digerir alimentos, fortalecen nuestro sistema inmunológico y nos protegen contra los gérmenes invasores. Pero en apenas un puñado de generaciones hemos podido observar una pérdida asombrosa de diversidad microbiana que puede verse reflejada, por ejemplo, con el aumento de trastornos inmunes", añade la investigadora.
Microorganismos en peligro
El manifiesto se inicia constatando una realidad que, por invisible, permanece oculta: muchos de los microorganismos esenciales para la salud humana están en riesgo. De acuerdo con los investigadores, estas formas de vida microscópica estarían siendo amenazadas por diferentes procesos característicos de la vida moderna. Es el caso, por ejemplo, del abuso de antibióticos y la extensión de las dietas altas en grasas o basadas en alimentos ultraprocesados. Unos factores que, de acuerdo con los investigadores, estarían relacionados con la pérdida de diversidad de microorganismos y que a largo plazo podrían suponer un riesgo para la salud global.
Una clara muestra de ello podría ser, según explican los investigadores, el aumento de enfermedades autoinmunes y metabólicas relacionadas directamente con alteraciones de la microbiota humana. "Por ahora tenemos evidencias de una correlación entre grados de urbanización y pérdida de la diversidad. Sabemos que, por ejemplo, cuanto más extendida esté la medicina en una sociedad, menos diversidad microbiota intestinal tienen sus habitantes", explica Domínguez-Bello. "En estudios con animales sí que se ha observado una relación directa entre factores como la dieta o los antibióticos y la pérdida de microorganismos, por lo que necesitamos empezar a almacenar los microorganismos presentes en humanos hasta que tengamos clara su función", añade la investigadora.
Los impulsores de esta nueva iniciativa apuntan a que tan solo ahora estamos empezando a presenciar los daños colaterales de esta pérdida de diversidad. En este sentido, los expertos advierten: la pérdida microbiana mundial podría ser comparable con el cambio climático en términos de importancia para el futuro de la humanidad, por lo que se necesita tomar medidas globales para lidiar con este problema.
El último oasis
¿Pero cómo recuperar una biodiversidad que, por lo que parece, ya está perdida? El proyecto llama a iniciar un proceso de recolección de microbios beneficiosos para la especie humana que sobrevivan en poblaciones remotas del mundo. Lugares como los poblados aislados de América Latina y África podrían convertirse en el último oasis de microorganismos esenciales para la salud pero en vías de desaparición en la mayoría de poblaciones urbanas. "Nuestra idea es poder crear colecciones locales en cada uno de estos lugares en las que almacenar la gran diversidad microbiota existente. Al menos hasta que tengamos clara su función e investiguemos de qué manera podríamos restaurarla enfrentarnos a algunos de los problemas de salud actuales", explica Domínguez-Bello.
En este sentido, investigaciones anteriores han revelado que, por ejemplo, la flora intestinal de la mayoría de los estadounidenses es la mitad de diversa que la de los cazadores-recolectores de los Yanomamis, un pueblo indígena aislado en el corazón de la Amazonia.
La historia se repite
La iniciativa toma su nombre (o al menos su referencia popular) del conocido relato bíblico en el que se narra la historia de Noé, quien por encargo divino construyó un arca en la que recogió dos ejemplares de cada especie animal ante la inminente llegada de un diluvio universal. Esta misma idea de un refugio para salvaguardar las formas de vida en peligro de extinción ha acompañado la humanidad en algunas de sus etapas más convulsas.
En plena Segunda Guerra Mundial, un equipo de científicos rusos empezó en secreto un banco de semillas en el que recoger la mayor muestra de biodiversidad posible. En este caso, la amenaza nuclear amenazaba con la supervivencia del planeta, por lo que fueron muchos los que se preocuparon por crear un almacén de alimentos (mejor dicho, de sus semillas) que asegurara la supervivencia de la humanidad y la seguridad alimentaria a largo plazo.
Ya en época de paz, hacia 1996, más de 150 países se comprometieron a impulsar el conocido como Plan de Acción Mundial (GPA, por sus siglas en inglés) para garantizar la conservación de la diversidad de cultivos del planeta. De ahí surgió el Banco Mundial de Semillas de Svalbard (también llamado como Bóveda Global de Semillas): la colección más grande del mundo de especies relacionadas con el consumo humano que puedan rescatarse en caso de desastres naturales o provocados por el hombre.
Los impulsores de esta nueva iniciativa, bautizada como Arca de Noé de los microbios, reconocen que el proyecto se inspira, en parte, en esta última conocida iniciativa mediante la cual, según las últimas estimaciones, ya se conservan muestras de más de 930.821 especies. Recogiendo este mismo espíritu, ahora los investigadores reclaman un compromiso global para recopilar y proteger los amenazados microorganismos considerados como unas minúsculas herramientas esenciales para la vida.
- Muere Itxaso Mardones, reportera de Gloria Serra en 'Equipo de investigación', a los 45 años
- Hacienda te devuelve 300 euros si tienes un hijo menor de 25 años y 900 si tienes dos: así tienes que ponerlo en la declaración de la renta
- ¿Llamadas que cuelgan? Así son las robollamadas, la nueva táctica de spam telefónico
- Adiós a los cajones de la cocina: la solución con perchas que puedes colocar en cualquier parte
- Sánchez se plantea renunciar y convocar elecciones tras la investigación a su esposa
- La querella del novio de Ayuso se admitirá a trámite pese a la campaña del fiscal para que sea rechazada
- El CIS publica una encuesta sobre las elecciones en Catalunya a pocas horas del comienzo de la campaña
- Pedro Sánchez se plantea renunciar como presidente del Gobierno tras la investigación a su mujer